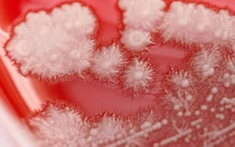
Người đàn ông "họng trắng như tuyết" vì thói quen này của nhiều người

cảm lạnh
Người đàn ông "họng trắng như tuyết" vì thói quen này của nhiều người
Tin tổng hợpKhi đến bệnh viện kiểm tra, bác sĩ nội soi phát hiện toàn bộ thành họng bệnh nhân xuất hiện vô số mảng trắng nhỏ, dày đặc như “lớp tuyết phủ”.

Bé trai 9 tuổi gần như bị mù sau khi bị cảm lạnh
Tin tổng hợpHốc mắt của cậu bé đỏ ngầu, sưng tấy và đau nhức, hóa ra là do viêm mô tế bào.

Không biết mình bị cảm lạnh hay biến thể Covid-19 mới, bác sĩ: Cảnh giác nếu có "những" triệu chứng này
Tin tổng hợpDịch Covid-19 đang tiếp tục diễn biến phức tạp. Với khả năng lây lan mạnh của biến thể Covid-19 mới, làm thế nào để phân biệt giữa cảm lạnh thông thường và nhiễm Covid-19?

5 điểm khác biệt giữa cảm lạnh và cúm, khi nào cần đi viện
Tin tổng hợpTin tức Từ Hy Viên qua đời vì viêm phổi do cúm ở Nhật Bản khiến nhiều người đặt câu hỏi cúm khác gì cảm lạnh? Khi nào nên đi viện khi bị cúm?

21 tuổi tim đã ngừng đập vì 1 thứ hiếm người trẻ nào không đối mặt hàng ngày
Tin tổng hợpGiữa nhịp sống hiện đại, người trẻ tuổi phải đối mặt với rất nhiều kiểu áp lực. Đây cũng là nguyên nhân nhiều bệnh tật “thích” nhắm vào nhóm người này.
